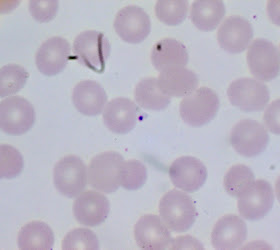

This week's case was generously donated by Florida Fan. The following are seen on Giemsa-stained thick and thin blood films. No history is immediately available. Diagnosis? Any additional information you would like?
Monday, July 29, 2019
Sunday, July 28, 2019
Answer to Case 554
Answer to Parasite Case of the Week 554: Babesia species. Without a travel history, the differential diagnosis includes Plasmodium falciparum malaria given that only ring forms are seen and there is a high parasitemia; however, the following features are supportive of babesiosis:
1. Multiple (4) small forms within a single cell that are not a clear schizont form of Plasmodium.
2. Easily-identified extracellular forms.
3. Lack of malaria pigment
As Blaine mentioned, the rings are not thin and delicate as would normally be seen with P. falciparum infection. While thicker rings are commonly seen in 'older' blood (i.e., blood that was >24 hours old), we would expect to see malaria pigment in these cases, and none is seen in this case.
One reader was favoring babesiosis, but was swayed from this diagnosis by the lack of maltese cross (tetrad) forms. However, it's important to note that most cases of babesiosis will NOT have maltese cross forms. Instead, the diagnosis must be made on the other features listed above, in addition to the commonly-seen pleomorphism of the parasite forms in babesiosis. Interestingly there wasn't a lot of pleomorphism in this case.
Thanks again to Florida Fan for donating this informative case. It reinforces the need to get a travel history whenever possible (he later learned that the patient had not traveled outside of the United States), and to consider both babesiosis and malaria in the differential when seeing intraerythrocytic parasites.
1. Multiple (4) small forms within a single cell that are not a clear schizont form of Plasmodium.
2. Easily-identified extracellular forms.
3. Lack of malaria pigment
As Blaine mentioned, the rings are not thin and delicate as would normally be seen with P. falciparum infection. While thicker rings are commonly seen in 'older' blood (i.e., blood that was >24 hours old), we would expect to see malaria pigment in these cases, and none is seen in this case.
One reader was favoring babesiosis, but was swayed from this diagnosis by the lack of maltese cross (tetrad) forms. However, it's important to note that most cases of babesiosis will NOT have maltese cross forms. Instead, the diagnosis must be made on the other features listed above, in addition to the commonly-seen pleomorphism of the parasite forms in babesiosis. Interestingly there wasn't a lot of pleomorphism in this case.
Thanks again to Florida Fan for donating this informative case. It reinforces the need to get a travel history whenever possible (he later learned that the patient had not traveled outside of the United States), and to consider both babesiosis and malaria in the differential when seeing intraerythrocytic parasites.
Monday, July 22, 2019
Case of the Week 553
This week's (interesting but somewhat disturbing) case was generously donated by Dr. José A. T. Poloni. The following was submitted from a fresh (unfixed) stool specimen. Most likely identification?
Sunday, July 21, 2019
Answer to Case 553
Answer to Parasite Case of the Week 553: Ascaris lumbricoides
The overall appearance and large size of this nematode are strongly suggestive of A. lumbricoides, given that this is a human stool specimen. As Sam mentioned, examining the anterior end for the characteristic 3 fleshy lips common to all ascarids, and examination of the stool for eggs would allow for confirmation of the identification.
Here are some images from other cases to show these characteristic features:
Adult with 3 fleshy lips from Case of the Week 479:
Thanks to all that wrote in with the answer, and to Dr. Poloni for donating this case!
The overall appearance and large size of this nematode are strongly suggestive of A. lumbricoides, given that this is a human stool specimen. As Sam mentioned, examining the anterior end for the characteristic 3 fleshy lips common to all ascarids, and examination of the stool for eggs would allow for confirmation of the identification.
Here are some images from other cases to show these characteristic features:
Adult with 3 fleshy lips from Case of the Week 479:
Mammillated and decorticated eggs from Case of the Week 550
Thanks to all that wrote in with the answer, and to Dr. Poloni for donating this case!
Monday, July 15, 2019
Case of the Week 552
This week's case is from Blaine Mathison. The following were seen on a trichrome-stained stool specimen. They averaged 5 to 7 micrometers in greatest dimension. A Giardia antigen test was positive.
Identification?
Identification?
Sunday, July 14, 2019
Answer to Case 552
Answer to Parasite Case of the Week 552: Enteromonas hominis
This was a tough one! Not a surprise since it came from Blaine 😊
The organisms shown are small trophozoites, measuring only 5 to 7 micrometers in greatest dimension, and no cysts were seen, thus making identification a bit challenging. While I think that some of these trophozoites look a bit like Chilomastix mesnili (for example, some of the larger forms in the first image), I think that the smaller size, less elongated shape without a well-defined terminal point, and larger karyosome is more consistent with E. hominis.
The CDC doesn't have any good trophozoite photos on the DPDx webpage, but Henry Bishop kindly shared these following beautiful photos with me awhile back. They are a bit clearer than in the current case and nicely demonstrate the diagnostic features.
So what about that positive Giardia antigen? A bit of a red herring in this case. Giardia was actually present in this case, but not included in the images I presented.
This was a tough one! Not a surprise since it came from Blaine 😊
The organisms shown are small trophozoites, measuring only 5 to 7 micrometers in greatest dimension, and no cysts were seen, thus making identification a bit challenging. While I think that some of these trophozoites look a bit like Chilomastix mesnili (for example, some of the larger forms in the first image), I think that the smaller size, less elongated shape without a well-defined terminal point, and larger karyosome is more consistent with E. hominis.
The CDC doesn't have any good trophozoite photos on the DPDx webpage, but Henry Bishop kindly shared these following beautiful photos with me awhile back. They are a bit clearer than in the current case and nicely demonstrate the diagnostic features.
So what about that positive Giardia antigen? A bit of a red herring in this case. Giardia was actually present in this case, but not included in the images I presented.
Tuesday, July 9, 2019
Case of the Week 551
This week's case was generously donated by Florida Fan and is very appropriate for this time of the year!
The following objects were seen on a stool specimen that had been stained by Wright-Giemsa to look for fecal leukocytes (total magnification 1000x). Preliminary identification? What additional stain would you like to perform to confirm your diagnosis?
The following objects were seen on a stool specimen that had been stained by Wright-Giemsa to look for fecal leukocytes (total magnification 1000x). Preliminary identification? What additional stain would you like to perform to confirm your diagnosis?
Sunday, July 7, 2019
Answer to Case 551
Answer to Parasite Case of the Week 551: Cyclospora cayetanensis oocysts.
This is an unusual preparation in that we don't usually see C. cayetanensis oocysts in Giemsa-stained preparations. Therefore, confirmation using a conventional stain such as modified acid fast or modified safranin would be indicated. The diagnosis can be made by the shape and size (~8 micrometers) in diameter.
Thanks again to Florida Fan for sharing this interesting case!
This is an unusual preparation in that we don't usually see C. cayetanensis oocysts in Giemsa-stained preparations. Therefore, confirmation using a conventional stain such as modified acid fast or modified safranin would be indicated. The diagnosis can be made by the shape and size (~8 micrometers) in diameter.
Thanks again to Florida Fan for sharing this interesting case!
Monday, July 1, 2019
Case of the Week 550
Happy July everyone! Here is our first case of the month by Idzi Potters and the Institute of Tropical Medicine, Antwerp. The following objects were seen in a concentrated wet prep of a stool specimen from an international adoptee from Ethiopia. They measure approximately 60 micrometers in greatest dimension. Identification?